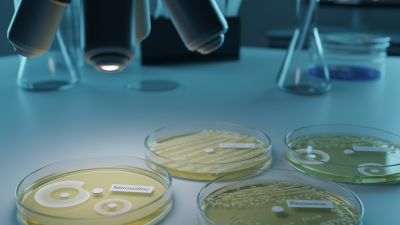
Nitroxoline Vs Other Antibiotics Which Is More Effective?

Leave Your Message
Nitroxoline And Liver Health is a topic gaining attention in wellness discussions. Many people seek natural solutions to improve liver function. Nitroxoline, an old antibiotic, is known for its surprising benefits beyond treating infections. Research suggests it may offer potential support for liver health.
In recent years, scientists have scrutinized the effects of Nitroxoline on liver conditions. Initial findings are promising, showing a reduction in liver inflammation and improved cellular function. These benefits deserve closer examination, especially for individuals suffering from liver ailments.
While the existing data is encouraging, more studies are necessary. The relationship between Nitroxoline and liver health is complex. One might wonder if this antibiotic’s benefits extend to chronic liver conditions. Further exploration will help clarify its role and effectiveness in promoting liver wellness.

Nitroxoline, an antimicrobial agent, has gained attention for its potential benefits beyond infection control. Recent studies suggest that it may play a crucial role in liver health. Research indicates that nitroxoline can help reduce liver inflammation and fibrosis. A study published in the Journal of Gastroenterology reported a noticeable decrease in liver enzymes among patients using nitroxoline. This is promising for those facing liver-related issues.
Inflammation is a key factor in liver diseases. Nitroxoline may help target inflammatory pathways, offering relief from chronic liver damage. Additionally, its potential to improve mitochondrial function is worth noting. A report from the Journal of Cellular Biochemistry emphasized the importance of mitochondrial health in liver regeneration. Improved mitochondrial function can lead to better energy production and reduced oxidative stress within liver cells.
However, not all data is conclusive. Some findings suggest only marginal benefits in advanced liver disease cases. More research is needed to fully understand the long-term effects of nitroxoline. While the potential exists, caution in its application is essential. Individuals should consult healthcare providers before considering new treatments. The path ahead appears promising, yet uncertainty remains.
Nitroxoline has been studied for its potential benefits in supporting liver health. One of its main mechanisms involves reducing oxidative stress. Oxidative stress can damage liver cells. By scavenging free radicals, nitroxoline may help preserve the integrity of these delicate cells. This action can promote overall liver function.
Another mechanism is the enhancement of bile production. Bile is crucial for digestion and detoxification. Increased bile flows can aid in the excretion of harmful substances. This process may also improve fat metabolism. When liver function improves, many other bodily functions benefit as well, illustrating the intricate connections within our systems.
Despite its promising attributes, some individuals may experience side effects. Mild gastrointestinal discomfort is possible. Regular monitoring and consultation with a healthcare provider are advisable. An awareness of how any supplement interacts with existing conditions is essential. Reflecting on personal health choices can lead to smarter decisions in the pursuit of well-being.

Nitroxoline, a synthetic antibiotic, has garnered attention for its potential benefits on liver health. Research suggests that Nitroxoline may reduce liver inflammation and improve liver function. Some studies indicate that it can help manage conditions like fatty liver disease. These findings hint at its possible role in supporting overall liver health.
In a recent study, researchers found that Nitroxoline could decrease markers of liver damage. This suggests a promising approach to liver care. However, the precise mechanisms behind these effects remain unclear. Further research is needed to fully understand how Nitroxoline works in the liver.
Tips for incorporating Nitroxoline into your health routine include consulting your healthcare provider. Monitoring liver function through regular blood tests is essential. Additionally, maintaining a balanced diet can amplify its benefits. Focus on incorporating fruits and vegetables, as they support liver detoxification. Always remember, a proactive approach to liver health involves more than just medication. It's a lifestyle choice.
Nitroxoline is gaining attention for its potential benefits in liver health. However, it's essential to consider the side effects and safety aspects. Some studies suggest it can cause gastrointestinal upset, such as nausea or diarrhea. These effects may hinder compliance, especially in sensitive individuals. Research has indicated that approximately 5-10% of users experience these issues, leading to discontinuation of the treatment.
Moreover, liver enzymes should be monitored when using nitroxoline. Elevated liver enzymes can indicate stress on the liver. A report from the Journal of Clinical Hepatology highlighted that some patients suffered liver abnormalities after prolonged use. Regular check-ups can help mitigate risks, but not all side effects are predictable. Individual variability makes it hard to understand the full impact of nitroxoline on liver health.
In rare cases, allergic reactions can occur. Symptoms may include rashes or itching. Though infrequent, these reactions require immediate medical attention. The overall safety profile of nitroxoline appears favorable, but caution is warranted. Users should consult healthcare professionals to weigh benefits against potential risks. This nuanced approach ensures that patients receive comprehensive care while minimizing adverse effects.
| Benefit | Description | Evidence Level | Potential Side Effects | Safety Considerations |
|---|---|---|---|---|
| Antioxidant Properties | Helps reduce oxidative stress in the liver. | Moderate | Nausea, headache. | Consult a physician if symptoms persist. |
| Anti-inflammatory Effects | May lower inflammation in liver tissues. | Moderate | Skin rash, dizziness. | Monitor for allergic reactions. |
| Supports Bile Production | May enhance bile production for digestion. | Low | Gastrointestinal discomfort. | Use with caution in those with bile duct issues. |
| Improved Metabolism | Helps in regulating fat metabolism in the liver. | Moderate | Fatigue, changes in appetite. | Monitor weight and diet changes. |
| Detoxification Support | Aids the liver in detoxifying harmful substances. | High | Nausea, abdominal pain. | Avoid excessive use. |
| Inhibition of Pathogens | May help combat liver infections. | Moderate | Allergic reactions. | Consult with a healthcare provider. |
| Hepatoprotective Effects | Protects liver cells from damage. | High | Liver enzyme elevation. | Regular monitoring required. |
| Regulation of Blood Sugar | May assist in controlling blood glucose levels. | Moderate | Hypoglycemia. | Monitor blood sugar levels. |
| Supports Weight Management | May facilitate weight loss efforts. | Low | Weight fluctuations. | Combination with diet is crucial. |
| Overall Health Improvement | May enhance general well-being. | Low | Minor side effects. | Maintain a healthy lifestyle. |
Nitroxoline has gained attention for its potential benefits in supporting liver health. Unlike many other supplements, it works through unique mechanisms. It may help reduce oxidative stress in liver tissues. This is crucial, as oxidative stress can lead to liver damage over time.
When comparing Nitroxoline to other liver health supplements, a few differences emerge. Some supplements focus on promoting bile production or aiding digestion. However, Nitroxoline may have more direct effects on cellular health. While it shows promise, the research is still developing. Not all studies reach the same conclusions, and results can vary.
Choosing the right supplement can be challenging. Many people often overlook side effects and interactions. It’s important to consider personal health conditions. Consulting with a healthcare professional is wise. Some find that Nitroxoline works better for them than others. Yet, it can be frustrating when results do not meet expectations. Each body responds differently, highlighting the need for individualized approaches in liver health management.